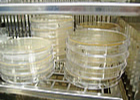

マーメイド ミスティア ピールリムーバー
[MERMAID MISTIOR PEEL REMOVER]










当社化粧品の基本的な製造工程
 |
1) 原料・資材受入検査 納入された原料・資材の品質をしっかりと確認します。 |
 |
2) バルク製造(攪拌混合・乳化) 製品ごとに個別に設定された製造手法を用いて製造を行います。 |
 |
3) 製造装置の洗浄 一度使用された製造装置は、その度に「分解・洗浄・乾燥・消毒」が行われていま |
 |
4) バルク検査 出来上がった中身は試験室で厳密に検査されます。製品ごとに設定された検査項目の全てに合格したもののみが次の工程へと進みます。 |
 |
5) 洗瓶作業 せっかく中身をきれいに仕上げても、容器が汚ければ意味がありません。 |
 |
6) エージング エージングタンクで、7〜10日寝かします。その間に細菌試験・バルク検査。寝かすことにより熟成されます。 |
 |
7) 充填・包装 バルクを容器に充填し、ロット印字、シュリンク包装、化粧箱への梱包を行う工程です。 |
|
8) 製品検査 完成品をランダムに抜き取り、試験室で厳密に検査します。中身の検査はもちろん、この工程では製品全体を総合的に検査します。 |
 |
9) 出荷 すべての検査に合格すると、いよいよ製品が出荷されます。 |